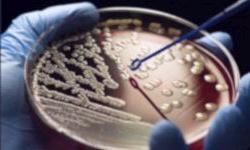
Тест подсказывает подходящий антибиотик

Тест подсказывает подходящий антибиотик
При лечении инфекционных заболеваний необходимо сначала выяснить, какие антибиотики окажут наибольшее действие на возбудителя. Однако этот способ требует определенного времени, поэтому зачастую назначаются лекарства, обладающие широким спектром действия. Они менее эффективны, чем средства, нацеленные на определенные микроорганизмы, а также ослабляют способность организма противостоять бактериям в будущем. Поэтому, средство, быстро выявляющее наличие определенных бактерий в крови или моче, было бы очень полезно для успешного лечения заболевания.
При лечении инфекционных заболеваний необходимо сначала выяснить, какие антибиотики окажут наибольшее действие на возбудителя. Однако этот способ требует определенного времени, поэтому зачастую назначаются лекарства, обладающие широким спектром действия. Они менее эффективны, чем средства, нацеленные на определенные микроорганизмы, а также ослабляют способность организма противостоять бактериям в будущем. Поэтому, средство, быстро выявляющее наличие определенных бактерий в крови или моче, было бы очень полезно для успешного лечения заболевания.
Подобный тест разработали британские ученые. Он включает в себя три слоя с разными функциями. Первый слой содержит четыре вида часто используемых антибиотиков, второй представляет собой впитывающую жидкость, а третий состоит из геля, обладающего благоприятными условиями для роста и развития бактерий.
Анализы больного пациента помещают во впитывающую жидкость среднего слоя. Если в крови или моче содержатся бактерии, то питательная среда третьего слоя позволяет им расти. А соприкасаясь со слоем, содержащим антибиотики, часть из этих бактерий убивается. Через некоторое время первый слой с антибиотиками начинает синеть, оставляя какую-нибудь область белой. Это означает, что антибиотик из этой области убивает выявленные бактерии и именно его нужно использовать для лечения заболевания.
Точность такого метода ниже, чем у полноценного лабораторного исследования. Однако этот способ недорогой и простой в использовании, а результат можно увидеть очень быстро.
Еще такой метод поможет снизить количество случаев, когда пациенту по ошибке назначался ненужный антибиотик. Кроме того, данный тест способен снизить скорость обретения бактериями устойчивости к антибиотикам.
Подробнее новейшие исследования в данной области мы разбираем на курсе повышения квалификации по клинической фармакологии.